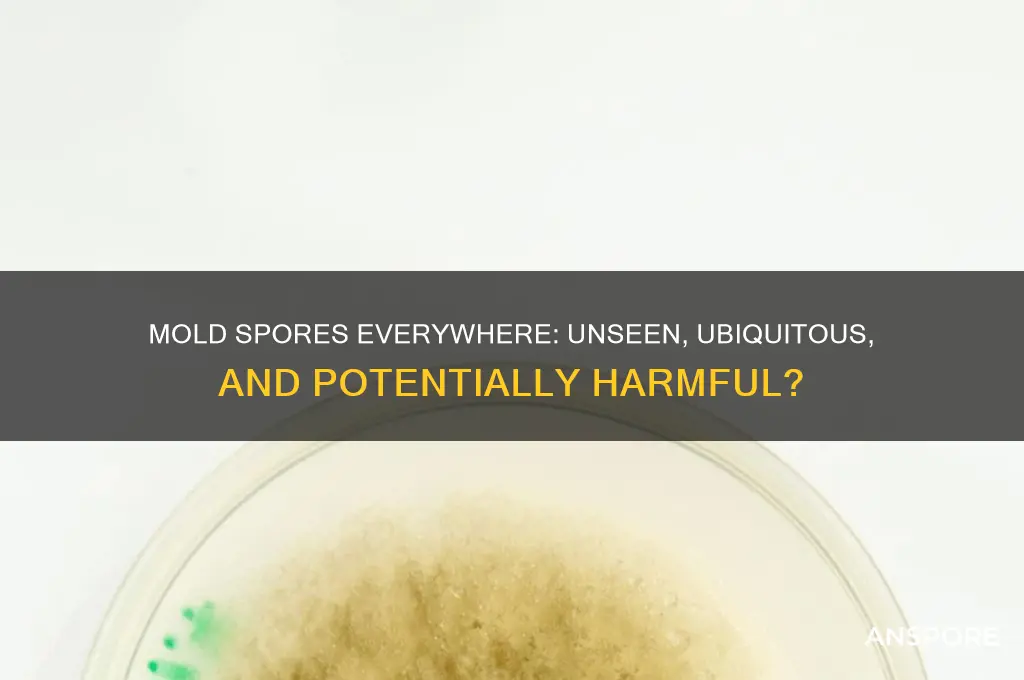
are mold spores just anywhere

Mold spores are ubiquitous in both indoor and outdoor environments, existing virtually everywhere on Earth. These microscopic particles are a natural part of the ecosystem, playing a crucial role in breaking down organic matter. However, their omnipresence raises questions about their impact on human health and daily life. While mold spores are generally harmless in low concentrations, they can proliferate in damp, humid conditions, leading to mold growth that may cause allergies, respiratory issues, or structural damage. Understanding their prevalence and behavior is essential for managing potential risks and maintaining healthy living spaces.
| Characteristics | Values |
|---|---|
| Ubiquity | Mold spores are ubiquitous and can be found almost everywhere in the environment, including indoors and outdoors. |
| Air Presence | They are present in the air we breathe, with outdoor concentrations typically higher than indoors. |
| Survival | Mold spores are highly resilient and can survive in harsh conditions, such as extreme temperatures and low humidity. |
| Size | They are microscopic, typically ranging from 2 to 100 microns in size, making them invisible to the naked eye. |
| Reproduction | Mold spores are reproductive units that can germinate and grow into new mold colonies when conditions are favorable (e.g., moisture, organic material). |
| Indoor Sources | Common indoor sources include damp areas like bathrooms, kitchens, basements, and areas with water damage or leaks. |
| Outdoor Sources | Outdoor sources include soil, decaying organic matter, plants, and airborne dispersal from natural environments. |
| Health Impact | While generally harmless in small quantities, high concentrations can cause allergic reactions, respiratory issues, and other health problems in sensitive individuals. |
| Detection | Specialized testing, such as air sampling or surface testing, is required to detect and quantify mold spore levels. |
| Prevention | Controlling indoor humidity, fixing leaks, and proper ventilation can help reduce mold spore growth and spread. |
Explore related products
What You'll Learn
- Indoor vs. Outdoor Presence: Mold spores exist both indoors and outdoors, thriving in damp, humid environments
- Airborne Distribution: Spores travel through air, easily spreading across surfaces and spaces
- Common Household Sources: Bathrooms, kitchens, and basements are hotspots due to moisture accumulation
- Health Risks: Prolonged exposure can cause allergies, respiratory issues, and other health problems
- Prevention Methods: Reduce humidity, fix leaks, and ventilate to limit spore growth

Indoor vs. Outdoor Presence: Mold spores exist both indoors and outdoors, thriving in damp, humid environments
Mold spores are ubiquitous, floating invisibly in the air both inside and outside our homes. This microscopic reality raises a critical question: where do these spores pose the greatest risk? The answer lies in understanding their preferred habitats. Outdoors, mold spores are part of the natural ecosystem, breaking down organic matter like leaves and wood. However, indoors, they become unwelcome guests, thriving in damp, humid environments that mimic their natural habitats. This duality highlights the importance of managing moisture levels in our living spaces to prevent these spores from settling and multiplying.
Consider the conditions that foster mold growth. Indoors, common culprits include leaky pipes, poorly ventilated bathrooms, and water-damaged walls. For instance, a shower without an exhaust fan can create a humidity level above 60%, the threshold at which mold spores begin to colonize surfaces. Outdoors, mold thrives in shaded, damp areas like compost piles or under decaying trees. While outdoor mold is generally less concerning, it can infiltrate homes through open windows, doors, or HVAC systems, especially in humid climates. This crossover underscores the need for proactive measures to control indoor humidity and seal potential entry points.
From a health perspective, the indoor presence of mold spores is particularly problematic. Prolonged exposure to indoor mold can exacerbate allergies, asthma, and respiratory issues, especially in vulnerable populations such as children, the elderly, and immunocompromised individuals. For example, the EPA recommends maintaining indoor humidity below 50% to inhibit mold growth. Practical steps include using dehumidifiers in basements, fixing leaks promptly, and ensuring proper ventilation in kitchens and bathrooms. These measures not only protect health but also preserve the structural integrity of buildings by preventing mold-related damage.
Comparing indoor and outdoor mold management reveals distinct strategies. Outdoors, controlling mold is largely about accepting its presence and minimizing its spread into living spaces. Simple actions like clearing gutters, trimming vegetation away from buildings, and avoiding overwatering plants can reduce outdoor mold sources. Indoors, the focus shifts to prevention and remediation. Regularly inspecting for water damage, using mold-resistant products in construction, and cleaning mold-prone areas with a solution of one cup of bleach per gallon of water are effective tactics. While outdoor mold is a natural phenomenon, indoor mold is a preventable hazard that requires vigilance and action.
In conclusion, while mold spores are indeed everywhere, their impact is determined by the environment they inhabit. Outdoors, they play a vital ecological role, but indoors, they become a health and structural threat. By understanding the conditions that allow mold to flourish and implementing targeted strategies, homeowners can mitigate risks and maintain healthier living spaces. The key takeaway? Mold spores may be omnipresent, but their indoor presence is controllable—and controlling them starts with managing moisture.
Effective Milky Spore Application: A Step-by-Step Guide for Lawn Grub Control
You may want to see also

Airborne Distribution: Spores travel through air, easily spreading across surfaces and spaces
Mold spores are microscopic, lightweight, and omnipresent in the air we breathe. Their size, typically ranging from 2 to 100 microns, allows them to remain suspended for extended periods, carried by even the gentlest air currents. This airborne nature is a key factor in their widespread distribution, enabling them to infiltrate homes, offices, and outdoor environments with ease. For context, a single cubic meter of air can contain thousands of mold spores, particularly in damp or humid conditions. Understanding this invisible movement is crucial for anyone looking to control mold growth, as spores can settle on surfaces and begin colonizing within 24 to 48 hours under favorable conditions.
To mitigate the spread of mold spores, consider the role of ventilation and air filtration. Proper airflow reduces spore concentration indoors, while HEPA filters in air purifiers can capture particles as small as 0.3 microns, effectively trapping spores. In spaces prone to moisture, such as bathrooms or basements, using exhaust fans or dehumidifiers can lower humidity levels below 60%, a threshold at which mold thrives. For those with allergies or respiratory sensitivities, monitoring spore counts through local weather reports or indoor air quality testers can help identify high-risk periods, allowing for proactive measures like closing windows or limiting outdoor activities during peak spore seasons.
Comparing indoor and outdoor environments highlights the adaptability of mold spores. Outdoors, spores are part of the natural ecosystem, breaking down organic matter. However, when they enter indoor spaces, they encounter surfaces rich in cellulose—materials like wood, paper, and drywall—which become breeding grounds for mold colonies. The transition from outdoor air to indoor surfaces is seamless due to spores’ ability to hitchhike on clothing, pets, and even HVAC systems. This underscores the importance of regular cleaning and surface maintenance, particularly in areas where dust and debris accumulate, as these provide nutrients for spore germination.
A persuasive argument for addressing airborne spores lies in their health implications. Prolonged exposure to mold spores can exacerbate asthma, trigger allergies, and cause respiratory infections, especially in children, the elderly, and immunocompromised individuals. For instance, studies show that indoor mold exposure increases the risk of asthma development in children by up to 30%. By controlling spore distribution through air quality management, individuals can significantly reduce these health risks. Simple steps like vacuuming with a HEPA filter, wiping surfaces with mold-inhibiting solutions, and inspecting hidden areas like crawl spaces can make a substantial difference in maintaining a healthy indoor environment.
Finally, a descriptive perspective reveals the silent yet relentless nature of spore travel. Imagine a spore released from a decaying leaf outdoors, carried by a breeze through an open window, and settling on a damp windowsill. Within days, it forms a colony, releasing millions of new spores into the air. This cycle repeats, spreading to bookshelves, curtains, and even air ducts, creating a network of mold growth that can go unnoticed until it becomes a visible problem. This scenario illustrates why early detection and prevention are far more effective than remediation, emphasizing the need to treat airborne spores not as an inevitability but as a manageable risk through informed, consistent action.
Gymnosperms vs. Spores: Unraveling the Evolutionary Timeline of Plants
You may want to see also

Common Household Sources: Bathrooms, kitchens, and basements are hotspots due to moisture accumulation
Mold spores are ubiquitous, floating invisibly in the air both indoors and outdoors. However, their presence alone isn’t the problem—it’s where they land and find moisture that matters. Bathrooms, kitchens, and basements are prime real estate for mold growth due to their inherent humidity and water usage. In bathrooms, steam from showers and baths creates a damp environment ideal for spores to settle and multiply. Kitchens, with their sinks, dishwashers, and cooking activities, often experience water splashes and condensation, fostering mold on walls, under sinks, and around appliances. Basements, prone to poor ventilation and occasional leaks, become breeding grounds for mold on walls, floors, and stored items. Understanding these hotspots is the first step in preventing mold’s unwelcome takeover.
To combat mold in these areas, proactive measures are essential. In bathrooms, ensure proper ventilation by using exhaust fans during and after showers, and wipe down wet surfaces promptly. A squeegee on shower walls can remove excess water, while a dehumidifier can maintain humidity below 60%. Kitchens require regular inspection of areas prone to moisture, such as under sinks and around refrigerators. Fix leaks immediately, and clean spills promptly to deny mold the moisture it craves. For basements, invest in a dehumidifier and waterproof walls to prevent water seepage. Store items in plastic bins off the floor to avoid contact with potential moisture. These steps, while simple, can significantly reduce mold’s ability to thrive.
Comparing these spaces reveals a common enemy: stagnant moisture. Bathrooms and kitchens face frequent water use, while basements battle external factors like groundwater and humidity. Yet, the solution remains consistent—control moisture, improve airflow, and maintain cleanliness. For instance, while a bathroom may benefit from mildew-resistant shower curtains, a basement might need a sump pump to manage water intrusion. Each area demands tailored strategies, but the underlying principle is universal: deprive mold of its lifeline.
Persuasively, ignoring these hotspots can lead to costly repairs and health risks. Mold spores, when inhaled, can trigger allergies, asthma, and respiratory issues, particularly in children, the elderly, and those with compromised immune systems. The financial burden of mold remediation pales in comparison to the cost of prevention. For example, a $30 dehumidifier is a small price to pay to avoid thousands in mold removal and structural repairs. By focusing on these common household sources, homeowners can protect both their health and their investment.
Descriptively, imagine a bathroom where fogged mirrors and damp tiles create a haven for mold, or a basement with musty odors signaling hidden colonies behind walls. These scenarios are avoidable with vigilance and action. Picture instead a well-ventilated bathroom, a dry kitchen, and a basement free of dampness—spaces where mold has no chance to take hold. This vision is achievable through consistent maintenance and awareness of moisture’s role in mold’s lifecycle. By targeting these hotspots, homeowners can transform their living spaces into mold-resistant sanctuaries.
How Long Can Mold Spores Survive Without Moisture?
You may want to see also
Explore related products

Health Risks: Prolonged exposure can cause allergies, respiratory issues, and other health problems
Mold spores are ubiquitous, floating in the air both indoors and outdoors, making prolonged exposure nearly inevitable in certain environments. While short-term contact with mold spores is generally harmless for most people, extended exposure can lead to a range of health issues, particularly for vulnerable populations. Children, the elderly, and individuals with compromised immune systems or pre-existing respiratory conditions are at higher risk. For instance, prolonged inhalation of mold spores can exacerbate asthma symptoms, leading to increased frequency and severity of asthma attacks. Understanding the health risks associated with mold exposure is the first step in mitigating its impact.
One of the most common health effects of prolonged mold exposure is the development or worsening of allergies. Mold spores act as allergens, triggering immune responses such as sneezing, itching, and watery eyes. Over time, repeated exposure can sensitize individuals, making them more reactive to even small amounts of mold. For example, a study published in the *Journal of Allergy and Clinical Immunology* found that individuals living in mold-infested homes were 30-50% more likely to develop allergic rhinitis. To minimize this risk, it’s essential to maintain indoor humidity below 60%, regularly clean areas prone to moisture, and use air purifiers with HEPA filters to reduce spore concentration.
Respiratory issues are another significant concern, particularly for those with chronic lung conditions. Prolonged exposure to mold spores can cause or aggravate conditions like bronchitis, sinusitis, and even pneumonia in severe cases. For instance, *Aspergillus*, a common indoor mold, can lead to aspergillosis, a fungal infection affecting the lungs. This is especially dangerous for individuals with cystic fibrosis or COPD. Practical steps to reduce exposure include fixing leaks promptly, ensuring proper ventilation in damp areas like bathrooms and kitchens, and avoiding carpeting in basements or other moisture-prone spaces.
Beyond allergies and respiratory problems, prolonged mold exposure has been linked to systemic health issues. Mycotoxins, toxic substances produced by certain molds, can enter the body through inhalation or ingestion, leading to symptoms like fatigue, headaches, and even neurological problems. While rare, severe cases of mycotoxin exposure can result in conditions such as toxic mold syndrome, which mimics symptoms of fibromyalgia or chronic fatigue syndrome. To protect against these risks, it’s crucial to address mold growth at its source. Hiring professionals for mold remediation in severe cases and using mold-resistant products in construction can significantly reduce long-term exposure.
In conclusion, while mold spores are indeed everywhere, their health risks are not inevitable. By understanding the specific dangers of prolonged exposure—from allergies and respiratory issues to systemic health problems—individuals can take proactive steps to protect themselves. Regular monitoring of indoor environments, maintaining proper ventilation, and addressing moisture issues promptly are key to minimizing the health impacts of mold. For those in high-risk categories, consulting healthcare providers for personalized advice is also recommended. Awareness and action are the most effective tools in combating the hidden dangers of mold.
Fungal Spores: Key Players in Reproduction and Survival Strategies
You may want to see also

Prevention Methods: Reduce humidity, fix leaks, and ventilate to limit spore growth
Mold spores are ubiquitous, floating in the air both indoors and outdoors, but their presence doesn’t always spell trouble. The real issue arises when they land in damp, nutrient-rich environments and begin to colonize. Prevention hinges on disrupting the conditions they thrive in, primarily by controlling moisture. Reducing indoor humidity to below 60%—ideally between 30% and 50%—deprives spores of the water they need to grow. Use dehumidifiers in basements, bathrooms, and other prone areas, and ensure they’re regularly emptied and cleaned to prevent becoming a source of mold themselves. This simple measure can significantly curb spore proliferation, especially in climates with high ambient humidity.
Leaks, whether from pipes, roofs, or windows, are silent culprits that create the perfect breeding ground for mold. Even small, unnoticed drips can saturate walls, floors, or ceilings over time, fostering spore growth. Regularly inspect your home for signs of water damage, such as discoloration, warping, or musty odors. Fix leaks immediately, and thoroughly dry affected areas within 24–48 hours to prevent mold from taking hold. For larger leaks or flooding, consider professional remediation to ensure all moisture is removed, as hidden dampness can persist long after surface drying.
Ventilation is another critical tool in the fight against mold. Stagnant, humid air traps moisture indoors, particularly in kitchens, bathrooms, and laundry rooms. Exhaust fans should be used during cooking, showering, and drying clothes to expel humid air outside. In areas without vents, opening windows can help, though this is less effective in high-humidity climates. For tighter homes, consider installing a whole-house ventilation system to ensure continuous air exchange. Proper airflow not only reduces moisture but also dilutes airborne spores, making it harder for them to settle and grow.
Combining these strategies creates a hostile environment for mold spores. For instance, in a bathroom prone to mold, install an exhaust fan rated for the room’s size (1 CFM per square foot is a good rule of thumb), fix any leaky faucets, and use a dehumidifier if needed. In basements, ensure proper grading around the foundation to prevent water seepage, use a dehumidifier, and install vents or fans to improve air circulation. While spores themselves are unavoidable, these proactive steps can limit their ability to cause harm, safeguarding both your home and health.
Are All Gram-Positive Bacteria Non-Spore Forming? Unraveling the Myth
You may want to see also
Frequently asked questions
Yes, mold spores are ubiquitous and can be found almost anywhere, both indoors and outdoors, as they are a natural part of the environment.
Yes, mold spores are highly resilient and can survive in harsh environments, including deserts and freezing temperatures, though they may remain dormant until conditions become favorable for growth.
No, it is impossible to completely eliminate mold spores from indoor spaces, as they constantly enter from the outdoors through air, dust, and other means.
No, mold spores do not affect everyone equally. Only certain individuals, such as those with allergies, asthma, or weakened immune systems, may experience health issues when exposed to mold spores.
Mold spores can grow anywhere there is moisture and a food source, regardless of cleanliness. However, maintaining low humidity and promptly fixing leaks can prevent them from thriving.

























